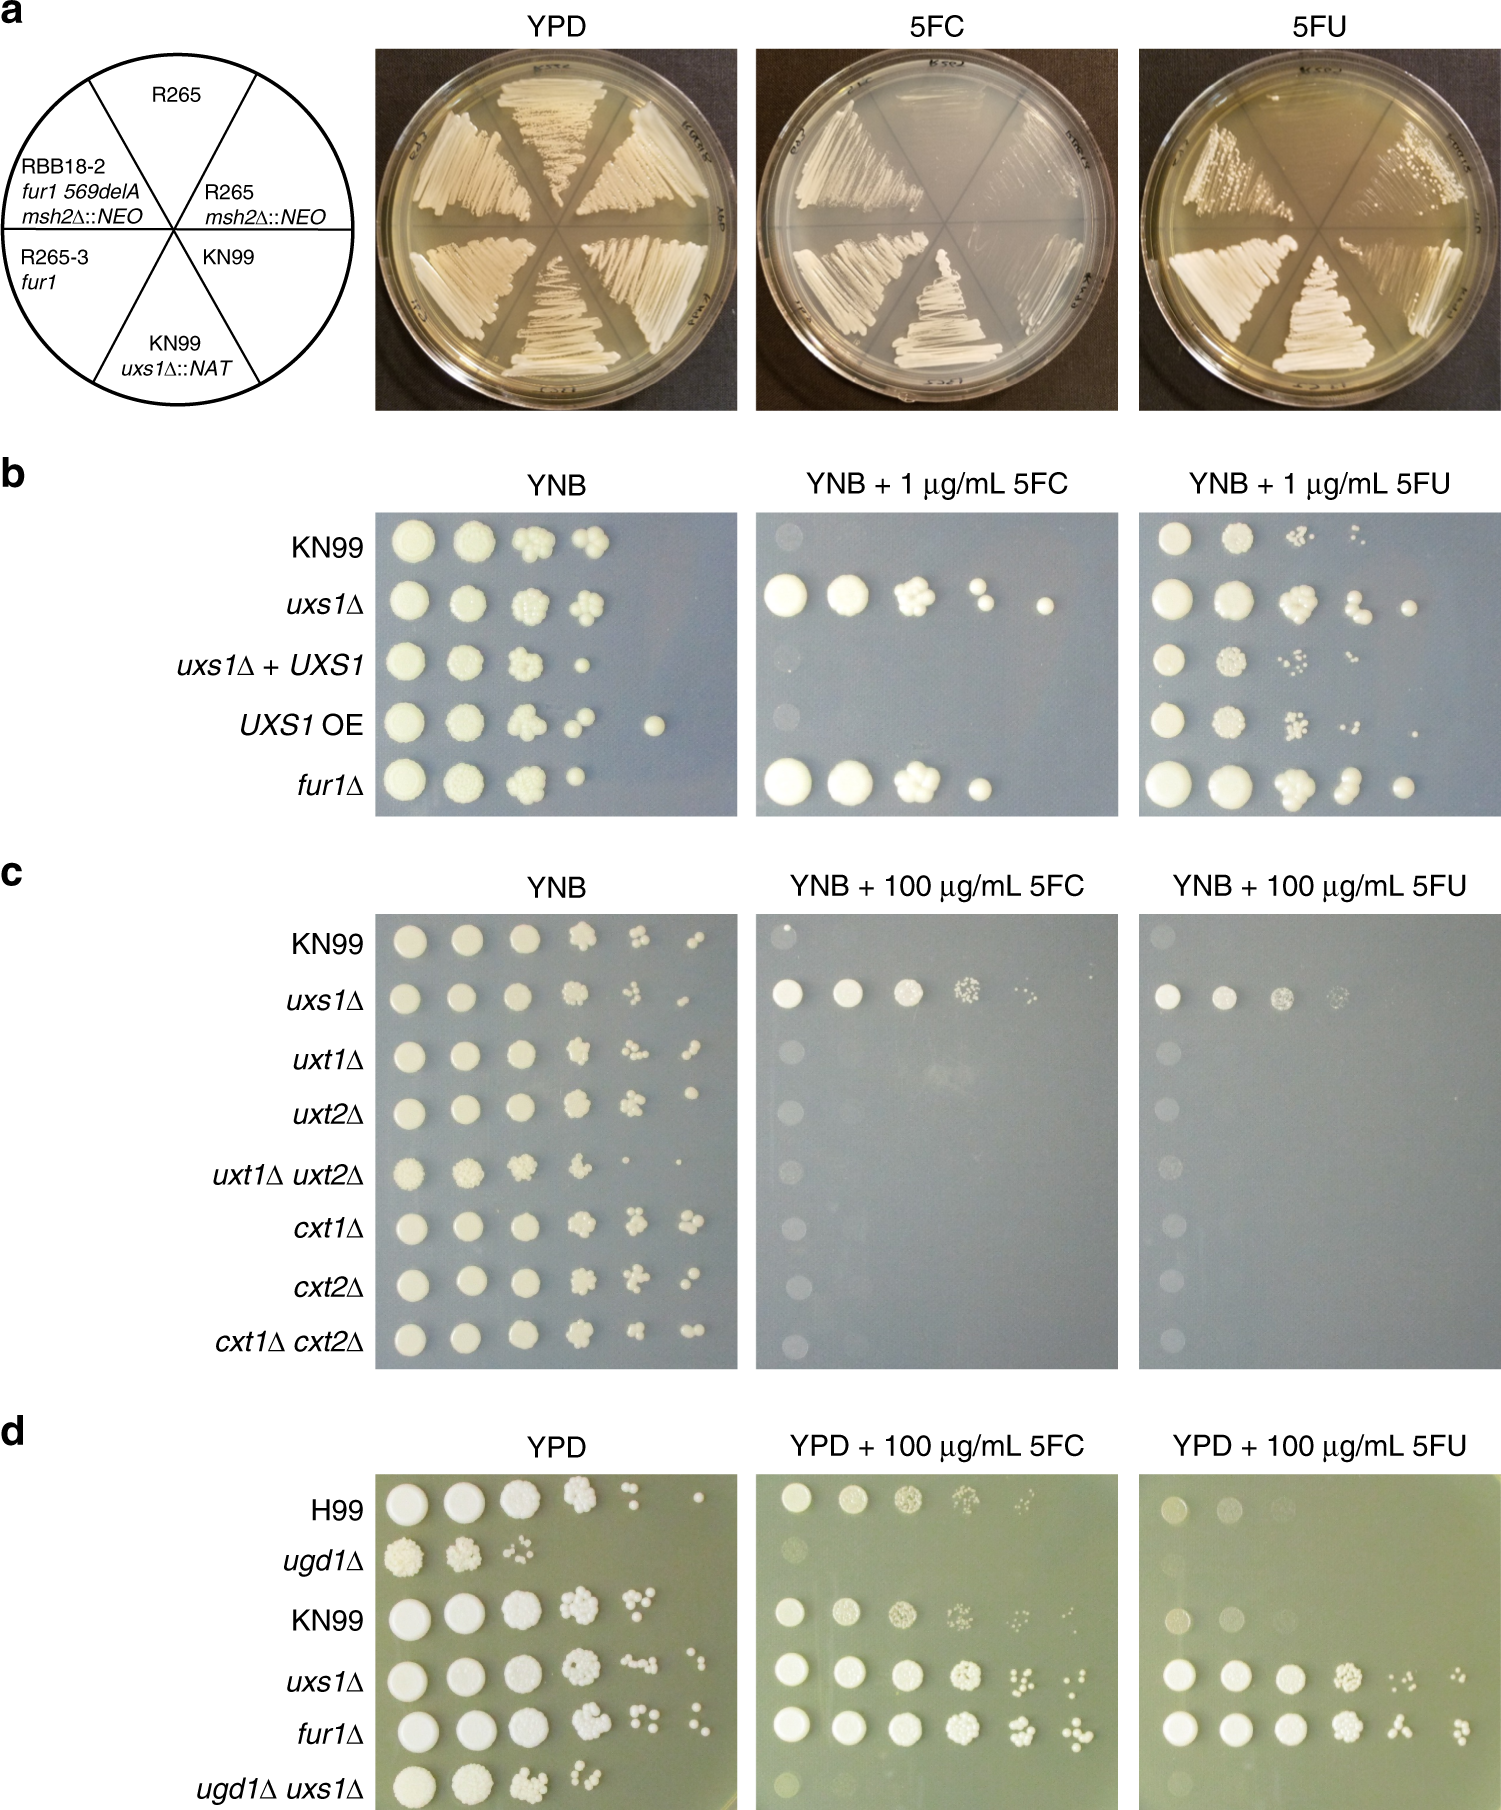
Fig. 4

Fig. 4: uxs1 mutants mediate 5FC resistance through a xylosylation-independent mechanism.
a KN99 deletion strains from the C. neoformans deletion collection show that deletion of UXS1 confers resistance to 5FC and 5FU. The RBB18-2 strain carrying a fur1 mutation is resistant to 5FC and 5FU although more weakly to 5FU. The R265-3 strain carrying a fur1 mutation is completely resistant to both drugs. b Spot dilution assay on YNB, YNB plus 5FC, and YNB plus 5FU demonstrating overexpression of UXS1 driven by the actin promoter does not confer increased sensitivity to 5FC or 5FU. c Spot dilution assays on YNB, YNB plus 5FC, and YNB plus 5FU demonstrating that mutants deficient in UDP-xylose transport (uxt1Δ, uxt2Δ, uxt1Δ uxt2Δ) and xylose transferase mutants (cxt1Δ, cxt2Δ, cxt1Δ cxt2Δ) show no change in 5FC and 5FU sensitivity. d Spot dilution assay on YPD, YPD plus 5FC, and YPD plus 5FU showing that ugd1 mutants are viable on rich YPD media but retain sensitivity to 5FC and 5FU. In addition, ugd1 uxs1 double mutants retain sensitivity to 5FC and 5FU like a ugd1 single mutant rather than gain resistance like the uxs1 single mutant.
